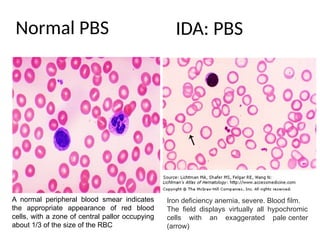
Normal PBS
Iron deficiency anemia, severe. Blood film.
The field displays virtually all hypochromic
cells with an exaggerated pale center
(arrow)
A normal peripheral blood smear indicates
the appropriate appearance of red blood
cells, with a zone of central pallor occupying
about 1/3 of the size of the RBC
IDA: PBS
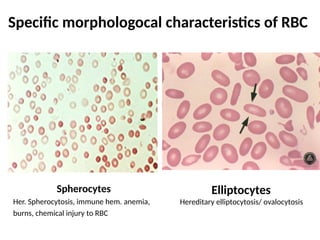
Specific morphologocal characteristics of RBC
Spherocytes
Her. Spherocytosis, immune hem. anemia,
burns, chemical injury to RBC
Elliptocytes
Hereditary elliptocytosis/ ovalocytosis
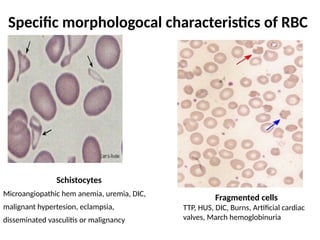
Specific morphologocal characteristics of RBC
Schistocytes
Microangiopathic hem anemia, uremia, DIC,
malignant hypertesion, eclampsia,
disseminated vasculitis or malignancy
Fragmented cells
TTP, HUS, DIC, Burns, Artificial cardiac
valves, March hemoglobinuria
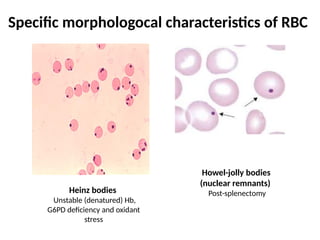
Specific morphologocal characteristics of RBC
Heinz bodies
Unstable (denatured) Hb,
G6PD deficiency and oxidant
stress
Howel-jolly bodies
(nuclear remnants)
Post-splenectomy

The document provides a comprehensive overview of anemia, including definitions, classifications, and causes of various types of anemia, as well as laboratory investigations and clinical presentations. It discusses specific types such as iron deficiency anemia, anemia of chronic disease, macrocytic anemias, and hemolytic anemias, alongside their respective pathophysiologies, diagnostic criteria, and treatment options. Key laboratory evaluations such as complete blood counts, peripheral blood smears, and reticulocyte counts are detailed to aid in clinical diagnosis and management of anemia.